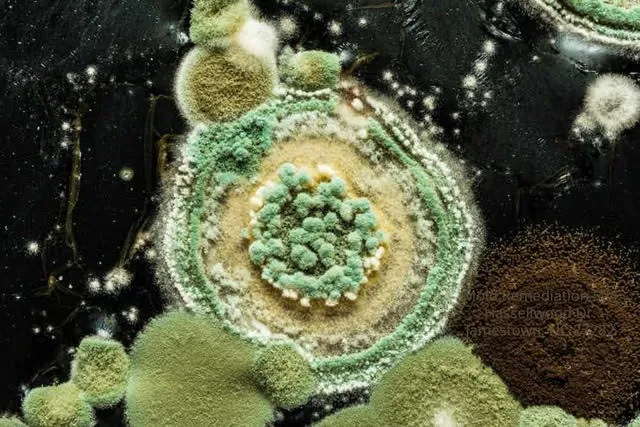
Greensboro Mold Remediation Inc Picture 8

Greensboro Mold Remediation Inc Photos

Greensboro Mold Remediation Inc Introduce
For homeowners and property managers across North Carolina, the discovery of mold can be a distressing experience. Beyond the unsightly appearance, mold can pose significant health risks and compromise the structural integrity of a building. When facing such an issue, the immediate need is for a highly skilled, thorough, and trustworthy general contractor specializing in mold remediation. In the heart of North Carolina, particularly in Greensboro, Greensboro Mold Remediation Inc. has established itself as a premier expert in tackling all types of mold concerns. This article aims to provide a clear, engaging, and informative overview of Greensboro Mold Remediation Inc., detailing their services, location, and why they are an outstanding choice for ensuring a clean, safe, and mold-free environment for North Carolina residents.
Greensboro Mold Remediation Inc. is a dedicated general contractor with a singular focus on comprehensive mold removal and prevention. They understand that mold growth is often a symptom of underlying moisture issues, and their approach is designed to address both the visible mold and its hidden sources. As highlighted by glowing customer reviews, their team of experts is renowned for being "really thorough" in their cleaning processes, leaving no stone unturned to ensure a completely mold-free environment. They are committed to restoring indoor air quality and creating healthier living and working spaces for their clients. Their professionalism, combined with an understanding of the urgency and sensitivity surrounding mold issues, ensures a smooth and stress-free experience from the initial inspection to the final cleanup. They pride themselves on delivering effective, long-lasting solutions that not only eliminate existing mold but also implement measures to prevent its return, safeguarding your property and your health.
Greensboro Mold Remediation Inc. is conveniently located at 217 W Market St, Greensboro, NC 27401, USA. This central downtown Greensboro location places them in an easily accessible spot for residents and businesses throughout the city and the broader Piedmont Triad region. Being situated on West Market Street, a key thoroughfare, ensures straightforward navigation for clients seeking their expertise. Their presence in the heart of Greensboro allows for efficient dispatch of their specialized teams to various residential and commercial properties, ensuring prompt and reliable service for all types of mold inspection and remediation needs. This local embedding strengthens their commitment to being an integral part of the North Carolina community, offering convenience and peace of mind for those facing mold challenges.
Greensboro Mold Remediation Inc. offers a specialized range of services designed to detect, remove, and prevent mold, ensuring a healthy and safe environment for homes and businesses. Their comprehensive approach addresses every aspect of mold contamination.
- Mold Inspection and Assessment: Thorough inspection of properties to identify visible mold and detect hidden moisture sources using advanced technologies, providing a clear understanding of the extent of the mold problem.
- Mold Removal and Remediation: Safe and effective removal of all types of mold, including black mold, from various surfaces such as walls, ceilings, and carpets. This involves using antifungal and antimicrobial treatments.
- Mold Containment: Implementing strict containment procedures, including turning off HVAC systems and using physical barriers like polyethylene sheeting, to prevent the spread and cross-contamination of mold spores during the remediation process.
- Air Filtration and Purification: Utilizing powerful "air scrubbers" and HEPA vacuums to capture microscopic mold spores from the air, significantly improving indoor air quality and preventing spore recirculation.
- Moisture Control and Drying: Setting up dehumidifiers and fans to thoroughly dry affected areas, eliminating the moisture that is essential for mold growth and preventing future outbreaks.
- Removal of Mold-Infested Materials: When necessary, safe and proper removal and disposal of heavily mold-infested porous materials such as drywall, carpeting, insulation, and other compromised building components.
- Cleaning and Sanitization: Comprehensive cleaning of structural elements (flooring, framing, fixtures, HVAC systems) and other items like curtains and décor that have been affected by mold.
- Restoration Services: Depending on the level of mold damage, minor repairs such as replacing drywall and painting, or major reconstruction of various areas or rooms in the property.
- Indoor Air Quality Testing: Offering testing services to assess indoor air quality before and after remediation to ensure that the environment is safe and contaminant-free.
- Preventative Measures: Providing advice and implementing solutions to prevent future mold growth, addressing underlying humidity and moisture issues.
Greensboro Mold Remediation Inc. is distinguished by several key features and highlights that consistently earn them glowing reviews and strong recommendations from their clientele. These attributes underscore their commitment to effectiveness, client satisfaction, and affordability.
- Thorough and Comprehensive Service: Customers consistently praise their team of experts for being "really thorough in cleaning" and making sure "no mold was left," ensuring a complete and effective remediation.
- Smooth Process from Start to Finish: Clients highlight a "smooth" service experience, indicating efficient management and execution of projects from the initial inspection to the final cleanup.
- Expert Team and Knowledgeable Professionals: The company's "team of experts" is recognized for their deep understanding of mold issues and effective remediation techniques.
- Effective Mold Elimination: They successfully remove visible mold, including challenging cases like "black mold in my closet’s corner," leaving properties "clean and free of molds."
- Utilization of Specialized Equipment: The use of "dehumidifiers and fans" to ensure complete drying and mold removal is a testament to their professional approach and investment in effective tools.
- Budget-Friendly Pricing: A significant highlight for customers is their "budget-friendly prices," making professional mold remediation accessible without compromising on quality.
- High Customer Satisfaction: The repeated expression of being a "very satisfied customer" and receiving a "ten out of ten" rating clearly demonstrates exceptional client contentment.
- Strong Reputation and Trust: The fact that new clients found them due to "the best reviews" and then understood "why!" after experiencing their service speaks to a strong and reliable reputation within the community.
For those in North Carolina looking to connect with Greensboro Mold Remediation Inc., their contact information is readily available. Their physical address is 217 W Market St, Greensboro, NC 27401, USA. For immediate assistance, to book an inspection, or to inquire about their services, you can reach them directly via phone at (336) 502-7636. Additionally, a mobile phone contact is available at +1 336-502-7636. This direct accessibility ensures that both prospective and existing clients can easily get in touch with their dedicated team to discuss their mold concerns, schedule an assessment, or initiate remediation, reinforcing their commitment to transparent and open communication within the local community.
For locals across North Carolina, especially within the Greensboro area, Greensboro Mold Remediation Inc. stands out as an exceptionally suitable and highly recommended general contractor for all mold-related issues. Their specialized focus on mold remediation means they possess the specific expertise and equipment necessary to tackle these challenging problems effectively, unlike general contractors who may offer mold removal as just one of many services. The powerful testimonials from real customers, praising their "fantastic mold remediation service" and confirming their "thorough in cleaning" approach, provide concrete evidence of their commitment to quality and lasting results.
The fact that they are lauded for their "smooth service from start to finish," their ability to completely remove even "black mold," and their "budget-friendly prices" makes them an incredibly attractive option for any North Carolina homeowner or property manager. When facing the stress and potential health risks associated with mold, having a responsive, thorough, and affordable expert like Greensboro Mold Remediation Inc. to rely on offers immense peace of mind. They are not just removing mold; they are restoring the health and safety of homes and businesses in our community, solidifying their role as an essential local resource.
Greensboro Mold Remediation Inc Location
Greensboro Mold Remediation Inc
217 W Market St, Greensboro, NC 27401, USA
Greensboro Mold Remediation Inc Reviews
A friend told me about the fantastic mold remediation service of this company. I decided to see for myself and booked an appointment to inspect my home for any types of mold build up. I’m glad I did because their team of experts were really thorough in cleaning my house! They set up some dehumidifiers and fans to make sure no mold was left. A very satisfied customer right here!
Dec 13, 2022 · B.nagaraju NagarajuI’ve been looking for mold remediation professionals to remove the black mold in my closet’s corner. I found this company to have the best reviews and now I understand why! Their service was smooth from start to finish. They made sure that my condo was clean and free of molds. It’s also a big plus that they have budget-friendly prices. I rate them ten out of ten!
Dec 14, 2022 · Phillip BakerContracted Sam to remove mold found in basement walls safely. Due to extensive mold found after water damage, the walls must be completely removed and disposed of. Sam managed the project from the initial estimate to the removal of materials with two crew members assisting (Thomas & Robert). The project was handled quickly, thoroughly and safely. I would not hesitate to recommend Greensboro Mold Remediation Inc to anyone for this type of remediation project. 5 stars from us! They are the best mold remediation company in Greensboro!
Oct 14, 2021 · Caroline HardyWe needed a consultation to help us in budgeting the remediation work we’d need to perform on a house we were purchasing in Burlington. Brian went above and beyond to fit us in quickly and provided a detailed assessment, helping us with our expectations. When the time comes to remove the mold, Greensboro Mold Remediation, Inc will be the only call we’ll make. Thank you so much!
Apr 29, 2021 · Dominick FayThey showed up when they said they would. This Greensboro Mold Removal Inc did a great job with the mold problems in our bathroom. Fast and reasonably priced!
Dec 30, 2021 · Sharette Howarth
More Water Damage Restoration Near Me
Carolina Steam5.0 (141 reviews)233 N Spring St, Greensboro, NC 27401, USA
Tar Heel Basement Systems4.0 (75 reviews)611 Summit Ave #5, Greensboro, NC 27405, USA
AdvantaClean of The Piedmont4.0 (94 reviews)1316 Carolina St, Greensboro, NC 27401, USA
Greensboro Mold Removal Team5.0 (1 reviews)1175 Revolution Mill Dr #5, Greensboro, NC 27405, USA
Tim Moss & Sons Home Improvement4.0 (35 reviews)717 Green Valley Rd #200, Greensboro, NC 27408, USA
ATI Restoration4.0 (41 reviews)105 Industrial Ave, Greensboro, NC 27406, USA
Phase 3 Plumbing & Water Restoration4.0 (66 reviews)2922 Baltic Ave, Greensboro, NC 27406, USA
SERVPRO of Greensboro North4.0 (376 reviews)2902 Manufacturers Rd, Greensboro, NC 27406, USA
RestoPros of The Triad4.0 (36 reviews)107 Creek Ridge Rd B, Greensboro, NC 27406, USA
The Water Damage Pros Greensboro5.0 (34 reviews)2309 W Cone Blvd #120d, Greensboro, NC 27408, USA
Walsh Crawlspace & Structural Repair5.0 (18 reviews)2216 W Meadowview Rd Box 25, Greensboro, NC 27407, USA
911 Restoration of Greensboro4.0 (44 reviews)604 Industrial Ave, Greensboro, NC 27406, USA
Categories
Top Visited Sites
SERVPRO of Downtown Cincinnati/Team Phillips & Smith5.0 (46 reviews)
Paul Davis Restoration of Greater Seattle4.0 (91 reviews)
Coastal Claims Services5.0 (106 reviews)
ServiceMaster Water Extraction El Paso TX5.0 (2 reviews)
1st Class Construction, Inc.4.0 (37 reviews)
Beam Restoration5.0 (15 reviews)Top Water Damage Restoration Searches
Trending Damage Repair Guides Posts
How to Restore Water-Damaged Books and Papers: Expert Tips
How to Repair Water-Damaged Doors and Frames
Water Damage Restoration Techniques for Large Homes in the U.S.
How to Remove Mold After Water Damage: A Comprehensive Guide
Water Damage Repair for Kitchen Flooring: A Complete Guide
Water Damage Repair for Bathroom Flooring and Tile in the USA
